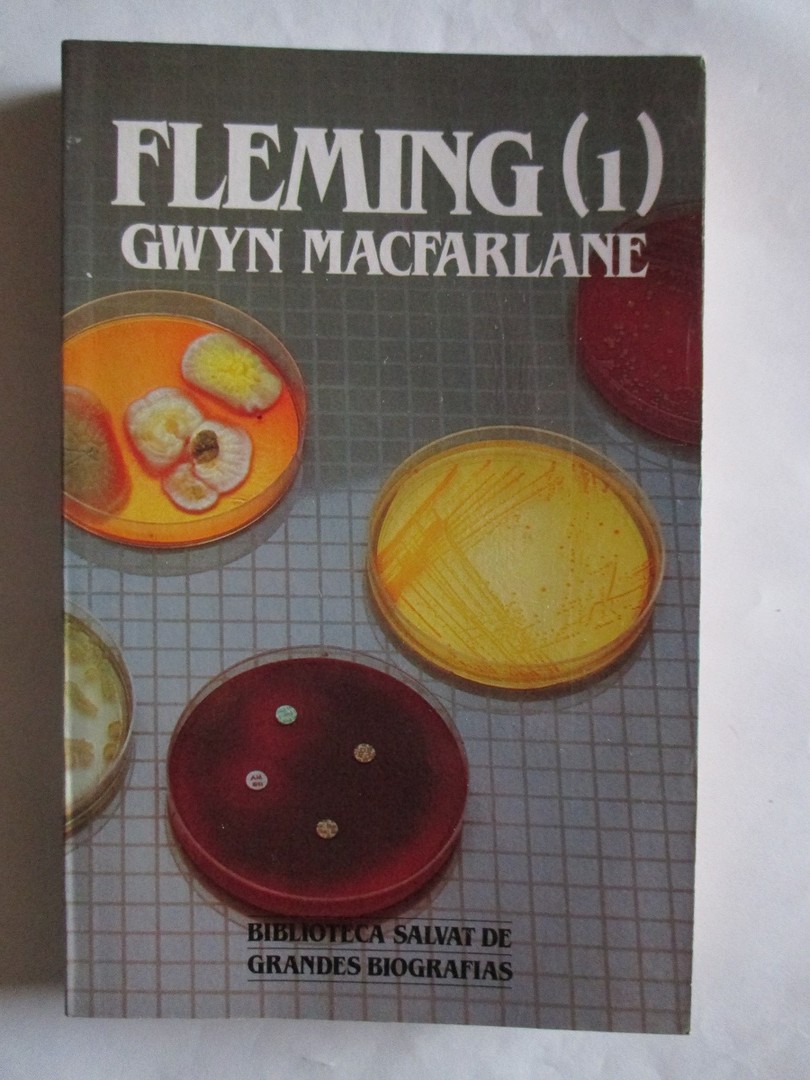
coverImage

Fleming (1) - MacFarlane, Gwyn
KORTE INHOUD
"{title}" is een boek van {author}. Het is uitgegeven door {publisher}. Deze editie verscheen in {publishYear}. Dit werk telt {countPages} pagina's. Het is geschreven in het {language}.
Deze editie wordt tweedehands aangeboden door {sellerCount} boekverkopers uit {sellerCities}. Voor meer info, bekijk de beschrijving van de beschikbare exemplaren verder op deze pagina.
Deze editie wordt tweedehands aangeboden door {sellerCount} boekverkopers uit {sellerCities}. Voor meer info, bekijk de beschrijving van de beschikbare exemplaren verder op deze pagina.

